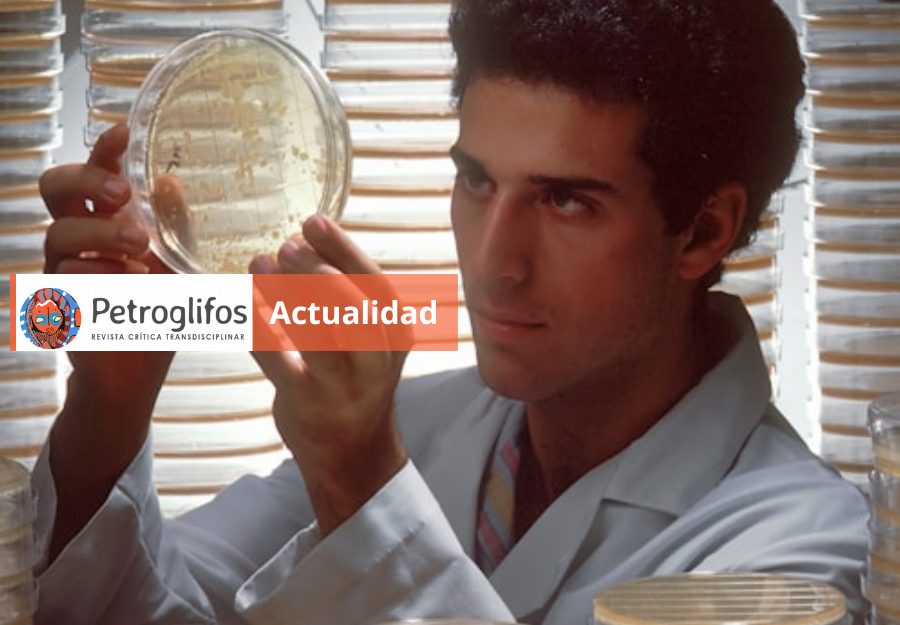

El data sharing es la práctica de poner a disposición de otros investigadores los datos no procesados, “crudos” o “raw data” de una investigación.
Estas son cuatro ventajas de esta práctica en la ciencia.
↗️Incrementa la transparencia de las investigaciones.
↗️ Facilita la extracción, validación e interpretación de resultados.
↗️Afianza la cultura colaborativa en los equipos de investigación.
↗️Maximiza la utilidad de los datos, al permitir que sean utilizados en otras investigaciones.
Hoy recomendamos y te compartimos este manual de Andrea Sixto Costoya et. al. (2019)
Descarga el manual completo aquí.